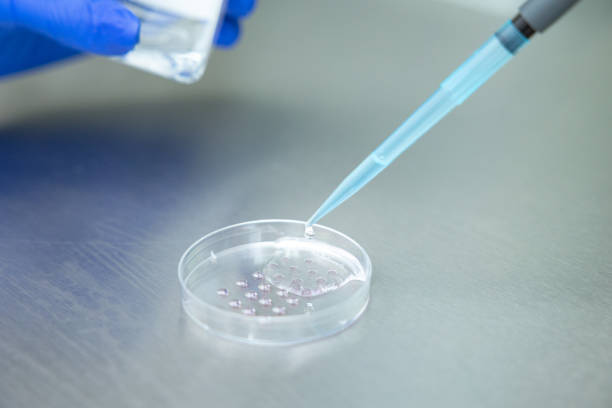
Updates

2023-08-07T05:17:37
Tags :
- team
- state
- dreams
- journey
- patient
- experts
- compassion
- parenthood
- excellence
- track record
- Obstetrician
- immense pride
- art facilities
- best IVF clinic
- highest chances
- success stories
- Finest IVF Centre
- Best IVF Services
- comforting ambiance
- Expert Gynecologists
- personalized approach
- renowned gynecologists
- infertility treatments
- cutting-edge techniques
- exceptional IVF services
- Leading Fertility Specialists
- Pimpri- Chinchwad Nucleus IVF
- Pimpri- Chinchwad Pioneering Infertility Solutions

Have a question? Ask here!
Required fields are marked *